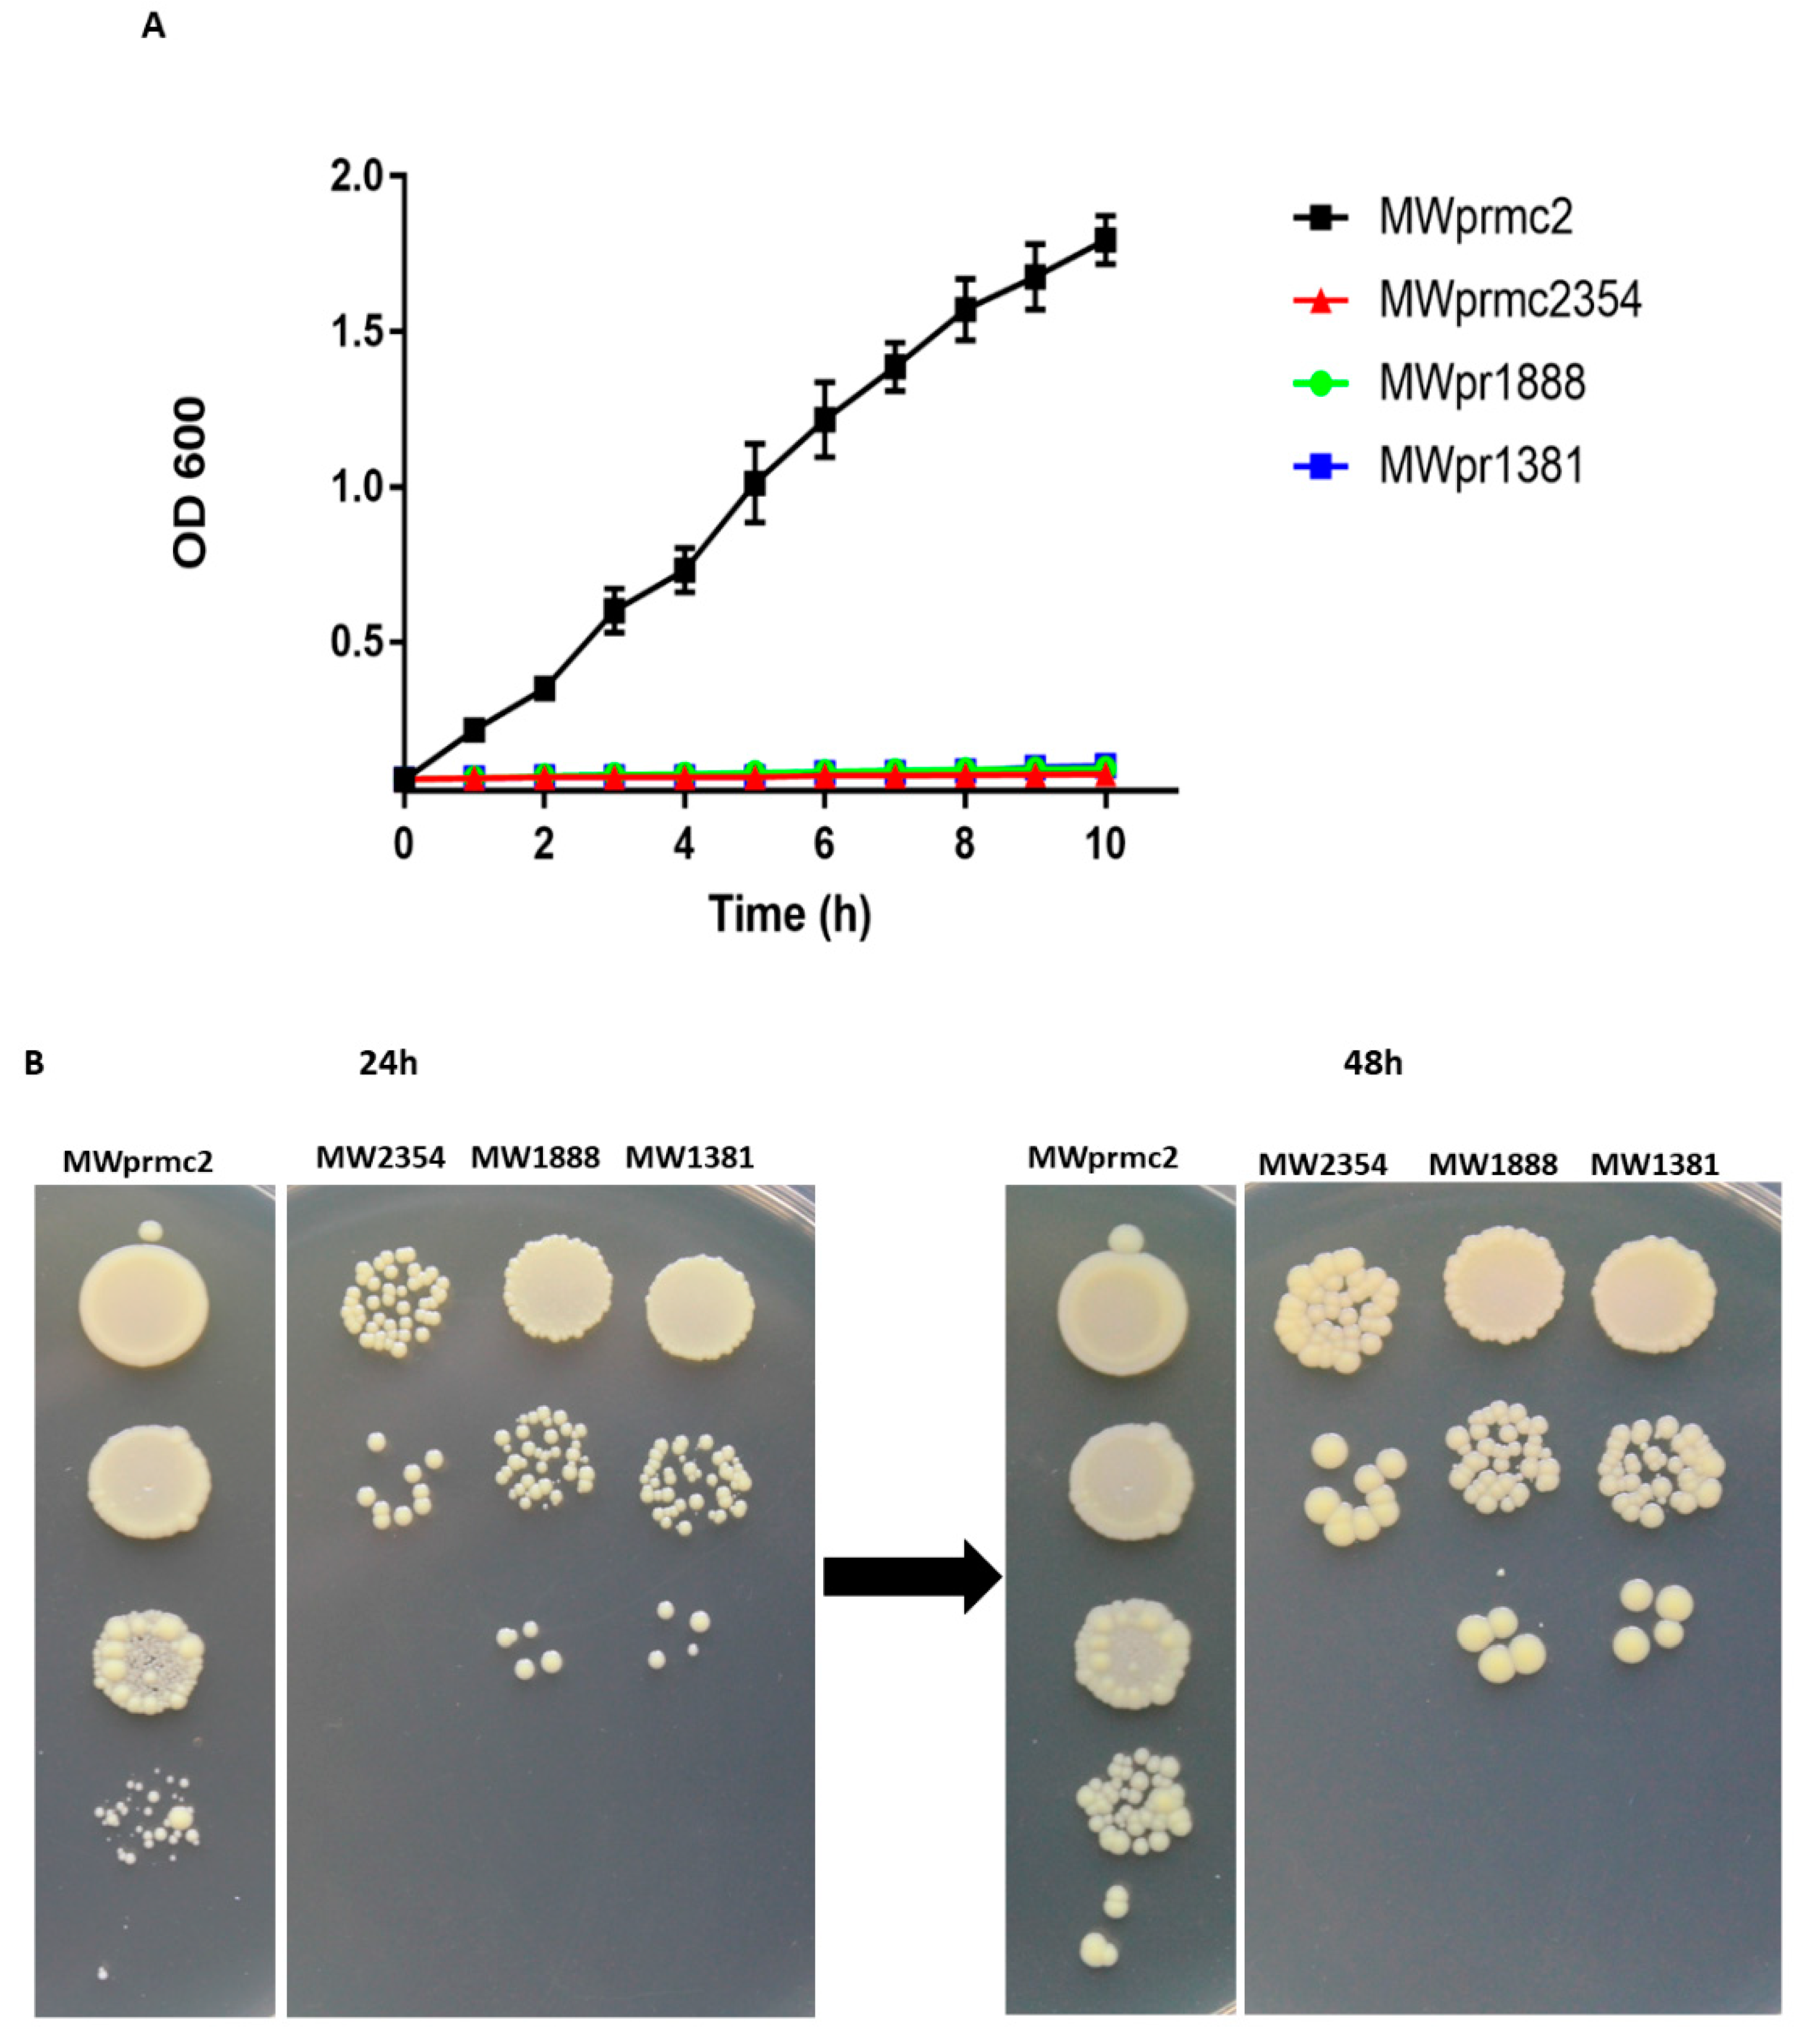
Toxins 10 00473 g007 Toxins 10 00473 g007

Bioinformatics and Functional Assessment of Toxin-Antitoxin Systems in Staphylococcus aureus
Abstract
1. Introduction
2. Results and Discussion
2.1. Comprehensive Screening of Toxin-Antitoxin Systems in S. aureus
2.2. Distribution of TA Genes in Different Families
2.3. Pathogenicity Islands TA Systems
2.4. Functional Assessment of the Type I TA System
2.5. Transmission Eelectron Microscopy Analysis of the Bacterial Cell Wall
2.6. Response and Function of Cellular Proteases in S. aureus
2.7. Functional Assessment of Type II TA Systems
3. Conclusions
4. Materials and Methods
4.1. Bacterial Strains and Growth Conditions
4.2. Screening of TA Systems in S. aureus
4.3. Construction of Vectors
4.4. Cellular Toxicity Assay
4.5. RNA Extraction and qRT-PCR
4.6. Preparation of Samples for Transmission Electron Microscopy
4.7. Gel-Shift Assay
4.8. Statistical Analysis
Supplementary Material
Author Contributions
Funding
Acknowledgments
Conflicts of Interest
References
- Baba, T.; Takeuchi, F.; Kuroda, M.; Yuzawa, H.; Aoki, K.; Oguchi, A.; Nagai, Y.; Iwama, N.; Asano, K.; Naimi, T.; et al. Genome and virulence determinants of high virulence community-acquired mrsa. Lancet 2002, 359, 1819–1827. [Google Scholar] [CrossRef]
- Fernandez-Garcia, L.; Blasco, L.; Lopez, M.; Bou, G.; Garcia-Contreras, R.; Wood, T.; Tomas, M. Toxin-antitoxin systems in clinical pathogens. Toxins 2016, 8, 227. [Google Scholar] [CrossRef] [PubMed]
- Schuster, C.F.; Bertram, R. Toxin-antitoxin systems of staphylococcus aureus. Toxins 2016, 8, 140. [Google Scholar] [CrossRef] [PubMed]
- Yamaguchi, Y.; Park, J.H.; Inouye, M. Toxin-antitoxin systems in bacteria and archaea. Annu. Rev. Genet. 2011, 45, 61–79. [Google Scholar] [CrossRef] [PubMed]
- Sala, A.; Bordes, P.; Genevaux, P. Multiple toxin-antitoxin systems in mycobacterium tuberculosis. Toxins 2014, 6, 1002–1020. [Google Scholar] [CrossRef] [PubMed]
- De la Cruz, M.A.; Zhao, W.; Farenc, C.; Gimenez, G.; Raoult, D.; Cambillau, C.; Gorvel, J.P.; Meresse, S. A toxin-antitoxin module of salmonella promotes virulence in mice. PLoS Pathog. 2013, 9, e1003827. [Google Scholar] [CrossRef] [PubMed]
- Page, R.; Peti, W. Toxin-antitoxin systems in bacterial growth arrest and persistence. Nat. Chem. Biol. 2016, 12, 208–214. [Google Scholar] [CrossRef] [PubMed]
- Wen, Z.; Wang, P.; Sun, C.; Guo, Y.; Wang, X. Interaction of type iv toxin/antitoxin systems in cryptic prophages of escherichia coli k-12. Toxins 2017, 9, 77. [Google Scholar] [CrossRef] [PubMed]
- Wang, X.; Lord, D.M.; Cheng, H.Y.; Osbourne, D.O.; Hong, S.H.; Sanchez-Torres, V.; Quiroga, C.; Zheng, K.; Herrmann, T.; Peti, W.; et al. A new type v toxin-antitoxin system where mrna for toxin ghot is cleaved by antitoxin ghos. Nat. Chem. Biol. 2012, 8, 855–861. [Google Scholar] [CrossRef] [PubMed]
- Kedzierska, B.; Hayes, F. Emerging roles of toxin-antitoxin modules in bacterial pathogenesis. Molecules 2016, 21, 790. [Google Scholar] [CrossRef] [PubMed]
- Aakre, C.D.; Phung, T.N.; Huang, D.; Laub, M.T. A bacterial toxin inhibits DNA replication elongation through a direct interaction with the beta sliding clamp. Mol. Cell 2013, 52, 617–628. [Google Scholar] [CrossRef] [PubMed]
- Yoon, S.H.; Park, Y.K.; Kim, J.F. Paidb v2.0: Exploration and analysis of pathogenicity and resistance islands. Nucleic Acids Res. 2015, 43, D624–D630. [Google Scholar] [CrossRef] [PubMed]
- Sevin, E.W.; Barloy-Hubler, F. Rasta-bacteria: A web-based tool for identifying toxin-antitoxin loci in prokaryotes. Genome Biol. 2007, 8, R155. [Google Scholar] [CrossRef] [PubMed]
- Xie, Y.; Wei, Y.; Shen, Y.; Li, X.; Zhou, H.; Tai, C.; Deng, Z.; Ou, H.Y. Tadb 2.0: An updated database of bacterial type ii toxin-antitoxin loci. Nucleic Acids Res. 2018, 46, D749–D753. [Google Scholar] [CrossRef] [PubMed]
- Fozo, E.M.; Makarova, K.S.; Shabalina, S.A.; Yutin, N.; Koonin, E.V.; Storz, G. Abundance of type i toxin-antitoxin systems in bacteria: Searches for new candidates and discovery of novel families. Nucleic Acids Res. 2010, 38, 3743–3759. [Google Scholar] [CrossRef] [PubMed]
- Lobato-Marquez, D.; Moreno-Cordoba, I.; Figueroa, V.; Diaz-Orejas, R.; Garcia-del Portillo, F. Distinct type i and type ii toxin-antitoxin modules control salmonella lifestyle inside eukaryotic cells. Sci. Rep. 2015, 5, 9374. [Google Scholar] [CrossRef] [PubMed]
- Andersen, S.B.; Ghoul, M.; Griffin, A.S.; Petersen, B.; Johansen, H.K.; Molin, S. Diversity, prevalence, and longitudinal occurrence of type ii toxin-antitoxin systems of pseudomonas aeruginosa infecting cystic fibrosis lungs. Front. Microbiol. 2017, 8, 1180. [Google Scholar] [CrossRef] [PubMed]
- Yeo, C.C. Gnat toxins of bacterial toxin-antitoxin systems: Acetylation of charged trnas to inhibit translation. Mol. Microbiol. 2018, 108, 331–335. [Google Scholar] [CrossRef] [PubMed]
- Schuessler, D.L.; Cortes, T.; Fivian-Hughes, A.S.; Lougheed, K.E.; Harvey, E.; Buxton, R.S.; Davis, E.O.; Young, D.B. Induced ectopic expression of higb toxin in mycobacterium tuberculosis results in growth inhibition, reduced abundance of a subset of mrnas and cleavage of tmrna. Mol. Microbiol. 2013, 90, 195–207. [Google Scholar] [PubMed]
- Wen, W.; Liu, B.; Xue, L.; Zhu, Z.; Niu, L.; Sun, B. Autoregulation and virulence control by the toxin-antitoxin system savrs in staphylococcus aureus. Infect. Immun. 2018, 86, IAI-00032. [Google Scholar] [CrossRef] [PubMed]
- Armalyte, J.; Jurenas, D.; Krasauskas, R.; Cepauskas, A.; Suziedeliene, E. The higba toxin-antitoxin module from the opportunistic pathogen acinetobacter baumannii—Regulation, activity, and evolution. Front. Microbiol. 2018, 9, 732. [Google Scholar] [CrossRef] [PubMed]
- Wood, T.L.; Wood, T.K. The higb/higa toxin/antitoxin system of pseudomonas aeruginosa influences the virulence factors pyochelin, pyocyanin, and biofilm formation. Microbiologyopen 2016, 5, 499–511. [Google Scholar] [CrossRef] [PubMed]
- Budde, P.P.; Davis, B.M.; Yuan, J.; Waldor, M.K. Characterization of a higba toxin-antitoxin locus in vibrio cholerae. J. Bacteriol. 2007, 189, 491–500. [Google Scholar] [CrossRef] [PubMed]
- Hurley, J.M.; Woychik, N.A. Bacterial toxin higb associates with ribosomes and mediates translation-dependent mrna cleavage at a-rich sites. J. Biol. Chem. 2009, 284, 18605–18613. [Google Scholar] [CrossRef] [PubMed]
- Nolle, N.; Schuster, C.F.; Bertram, R. Two paralogous yefm-yoeb loci from staphylococcus equorum encode functional toxin-antitoxin systems. Microbiology 2013, 159, 1575–1585. [Google Scholar] [CrossRef] [PubMed]
- Zheng, C.; Xu, J.; Ren, S.; Li, J.; Xia, M.; Chen, H.; Bei, W. Identification and characterization of the chromosomal yefm-yoeb toxin-antitoxin system of streptococcus suis. Sci. Rep. 2015, 5, 13125. [Google Scholar] [CrossRef] [PubMed]
- Sevillano, L.; Diaz, M.; Yamaguchi, Y.; Inouye, M.; Santamaria, R.I. Identification of the first functional toxin-antitoxin system in streptomyces. PLoS ONE 2012, 7, e32977. [Google Scholar] [CrossRef] [PubMed]
- Nieto, C.; Cherny, I.; Khoo, S.K.; de Lacoba, M.G.; Chan, W.T.; Yeo, C.C.; Gazit, E.; Espinosa, M. The yefm-yoeb toxin-antitoxin systems of escherichia coli and streptococcus pneumoniae: Functional and structural correlation. J. Bacteriol. 2007, 189, 1266–1278. [Google Scholar] [CrossRef] [PubMed]
- Cheverton, A.M.; Gollan, B.; Przydacz, M.; Wong, C.T.; Mylona, A.; Hare, S.A.; Helaine, S. A salmonella toxin promotes persister formation through acetylation of trna. Mol. Cell 2016, 63, 86–96. [Google Scholar] [CrossRef] [PubMed]
- Dalton, K.M.; Crosson, S. A conserved mode of protein recognition and binding in a pard-pare toxin-antitoxin complex. Biochemistry 2010, 49, 2205–2215. [Google Scholar] [CrossRef] [PubMed]
- De Jonge, N.; Garcia-Pino, A.; Buts, L.; Haesaerts, S.; Charlier, D.; Zangger, K.; Wyns, L.; De Greve, H.; Loris, R. Rejuvenation of ccdb-poisoned gyrase by an intrinsically disordered protein domain. Mol. Cell 2009, 35, 154–163. [Google Scholar] [CrossRef] [PubMed]
- Moyed, H.S.; Bertrand, K.P. Hipa, a newly recognized gene of escherichia coli k-12 that affects frequency of persistence after inhibition of murein synthesis. J. Bacteriol. 1983, 155, 768–775. [Google Scholar] [PubMed]
- Germain, E.; Castro-Roa, D.; Zenkin, N.; Gerdes, K. Molecular mechanism of bacterial persistence by hipa. Mol. Cell 2013, 52, 248–254. [Google Scholar] [CrossRef] [PubMed]
- Cooper, C.R.; Daugherty, A.J.; Tachdjian, S.; Blum, P.H.; Kelly, R.M. Role of vapbc toxin-antitoxin loci in the thermal stress response of sulfolobus solfataricus. Biochem. Soc. Trans. 2009, 37, 123–126. [Google Scholar] [CrossRef] [PubMed]
- Ramage, H.R.; Connolly, L.E.; Cox, J.S. Comprehensive functional analysis of mycobacterium tuberculosis toxin-antitoxin systems: Implications for pathogenesis, stress responses, and evolution. PLoS Genet. 2009, 5, e1000767. [Google Scholar] [CrossRef] [PubMed]
- Orth, D.; Grif, K.; Dierich, M.P.; Wurzner, R. Variability in tellurite resistance and the ter gene cluster among shiga toxin-producing escherichia coli isolated from humans, animals and food. Res. Microbiol. 2007, 158, 105–111. [Google Scholar] [CrossRef] [PubMed]
- Pandey, D.P.; Gerdes, K. Toxin-antitoxin loci are highly abundant in free-living but lost from host-associated prokaryotes. Nucleic Acids Res. 2005, 33, 966–976. [Google Scholar] [CrossRef] [PubMed]
- Li, G.; Shen, M.; Lu, S.; Le, S.; Tan, Y.; Wang, J.; Zhao, X.; Shen, W.; Guo, K.; Yang, Y.; et al. Identification and characterization of the hicab toxin-antitoxin system in the opportunistic pathogen pseudomonas aeruginosa. Toxins 2016, 8, 113. [Google Scholar] [CrossRef] [PubMed]
- Jorgensen, M.G.; Pandey, D.P.; Jaskolska, M.; Gerdes, K. Hica of escherichia coli defines a novel family of translation-independent mrna interferases in bacteria and archaea. J. Bacteriol. 2009, 191, 1191–1199. [Google Scholar] [CrossRef] [PubMed]
- Dy, R.L.; Przybilski, R.; Semeijn, K.; Salmond, G.P.; Fineran, P.C. A widespread bacteriophage abortive infection system functions through a type iv toxin-antitoxin mechanism. Nucleic Acids Res. 2014, 42, 4590–4605. [Google Scholar] [CrossRef] [PubMed]
- Short, F.L.; Akusobi, C.; Broadhurst, W.R.; Salmond, G.P.C. The bacterial type iii toxin-antitoxin system, toxin, is a dynamic protein-rna complex with stability-dependent antiviral abortive infection activity. Sci. Rep. 2018, 8, 1013. [Google Scholar] [CrossRef] [PubMed]
- Kopfmann, S.; Roesch, S.K.; Hess, W.R. Type ii toxin-antitoxin systems in the unicellular cyanobacterium synechocystis sp. Pcc 6803. Toxins 2016, 8, 228. [Google Scholar] [CrossRef] [PubMed]
- Feng, Y.; Chen, C.J.; Su, L.H.; Hu, S.; Yu, J.; Chiu, C.H. Evolution and pathogenesis of staphylococcus aureus: Lessons learned from genotyping and comparative genomics. FEMS Microbiol. Rev. 2008, 32, 23–37. [Google Scholar] [CrossRef] [PubMed]
- Pinel-Marie, M.L.; Brielle, R.; Felden, B. Dual toxic-peptide-coding staphylococcus aureus rna under antisense regulation targets host cells and bacterial rivals unequally. Cell Rep. 2014, 7, 424–435. [Google Scholar] [CrossRef] [PubMed]
- Sayed, N.; Nonin-Lecomte, S.; Rety, S.; Felden, B. Functional and structural insights of a staphylococcus aureus apoptotic-like membrane peptide from a toxin-antitoxin module. J. Biol. Chem. 2012, 287, 43454–43463. [Google Scholar] [CrossRef] [PubMed]
- Donegan, N.P.; Thompson, E.T.; Fu, Z.; Cheung, A.L. Proteolytic regulation of toxin-antitoxin systems by clppc in staphylococcus aureus. J. Bacteriol. 2010, 192, 1416–1422. [Google Scholar] [CrossRef] [PubMed]
- Valihrach, L.; Demnerova, K. Impact of normalization method on experimental outcome using rt-qpcr in staphylococcus aureus. J. Microbiol. Methods 2012, 90, 214–216. [Google Scholar] [CrossRef] [PubMed]
- Edgar, R.C. Muscle: Multiple sequence alignment with high accuracy and high throughput. Nucleic Acids Res. 2004, 32, 1792–1797. [Google Scholar] [CrossRef] [PubMed]

| Family | Toxin Genes | Length (aa) |
| TxpA/Fst/Holin (type I toxins) | MW1888-TxpA | 44 |
| MW2354-Fst | 84 | |
| MW0911-TxpA | 35 | |
| MW1440-TxpA | 34 | |
| MW0405 | 64 | |
| MW1434 | 81 | |
| MW1381-Holin | 100 | |
| Family | Toxin/Antitoxin Genes | Length (aa)Toxin/Anti-toxin |
| HigBA (type II) | MW1419/MW1418 | 84/57 |
| MW1725/MW1724 | 59/117 | |
| MW2494/MW2493 | 76/106 | |
| MW1228/MW1227 | 79/77 | |
| MW1413/MW1412 | 62/66 | |
| MW0749/MW0748 | 74/48 | |
| MW1338/MW1337 | 59/116 | |
| MW1928/MW1927 | 106/53 | |
| MW1397/MW1396 | 92/110 | |
| MW1822/MW1821 | 91/154 | |
| MW0789/MW0788 | 98/128 | |
| MW1919/MW1918 | 72/134 | |
| MW2464/MW2463 | 72/275 | |
| MW0907/MW0906 | 72/189 | |
| MW1056/MW1055 | 44/62 | |
| RelBE (type II) | MW2329/MW2330 | 88/83 |
| MW2380/MW2381 | 88/85 | |
| MW1230/MW1231 | 80/155 | |
| MW0324/MW0325 | 129/67 | |
| MW1394/MW1395 | 131/133 | |
| GNATs (type II) | MW2441/MW2440 | 94/144 |
| MW1089/MW1088 | 70/203 | |
| MW0641/MW0640 | 180/99 | |
| MW0924/MW0923 | 160/71 | |
| MW2449/MW2450 | 163/56 | |
| MW2497/MW2498 | 99/185 | |
| Nucleases (type II) (CcdAB/ParDE) | MW1311/MW1312 | 73/166 |
| MW0461/MW0462 | 87/130 | |
| MW1403/MW1402 | 104/101 | |
| MW1733/MW1732 | 85/159 | |
| VapBC (type II) | MW1070/MW1071 | 263/224 |
| MW0302/MW0303 | 266/315 | |
| MW0572/MW0573 | 211/295 | |
| MazEF (type II) | MW1992/MW1993 | 120/56 |
| MW1492/MW1493 | 114/144 | |
| HicBA (type II) | MW0075/MW0076 | 109/83 |
| MW0771/MW0772 | 72/94 | |
| Transporters (type II/IV) | MW1042/MW1043 | 61/77 |
| MW1045/MW1046 | 48/65 | |
| MW2414/MW2413 | 77/102 | |
| MW1722/MW1723 | 100/147 | |
| MW2025/MW2026 | 77/134 | |
| MW1779/MW1780 | 121/68 | |
| MW0350/MW0349 | 69/83 | |
| Transporters (type V/II) | MW2507/MW2506 | 91/122 |
| MW0268/MW0269 | 617/164 | |
| Abi (type III/IV) | MW2234/MW2233 | 245/104 |
| MW0420/MW0421 | 89/131 | |
| HipBA (type II) | MW0980/MW0981 | 91/179 |
| PTS (type II/IV) | MW1437/MW1436 | 133/107 |
| MW1004/MW1005 | 84/129 | |
| MW0777/MW0776 | 78/67 | |
| MW1150/MW1149 | 94/391 | |
| MW1196/MW1195 | 83/34 | |
| MW1292/MW1291 | 89/102 | |
| MW1432/MW1431 | 71/87 | |
| MW1164/MW1165 | 275/130 | |
| MW0101 | 50 | |
| MW0036 | 103 | |
| MW1827 | 128 |
| PIs | Size (bp) | Number of TA Systems | Representative Toxins from TA Systems | Virulence Genes in PIs |
|---|---|---|---|---|
| Phi-Sa-2 | 45,550 | 11 | MW1381, MW1394, MW1397, MW1403, MW1413, MW1419, MW1432, MW1434, MW1437, MW1440, MW1492 | Panton–Valentine leukocidin |
| VSa-gamma | 20,881 | 4 | MW1042, MW1045, MW1056, MW1070 | Alpha hemolysin, phenol soluble modulin |
| Phi-Sa-3 | 43,598 | 3 | MW1888, MW1919, MW1928 | Staphylokinase |
| VSa-beta | 31,977 | 3 | MW1725, MW1733, MW1779 | Proteases |
| VSa-alpha | 34,481 | 3 | MW0302, MW0324, MW0405 | -- |
| VSa-3 | 14,380 | 2 | MW0749, MW0771 | Enterotoxins, exotoxin |
| VSa-4 | 2710 | 0 | -- |
© 2018 by the authors. Licensee MDPI, Basel, Switzerland. This article is an open access article distributed under the terms and conditions of the Creative Commons Attribution (CC BY) license (http://creativecommons.org/licenses/by/4.0/).
Share and Cite
Habib, G.; Zhu, Q.; Sun, B. Bioinformatics and Functional Assessment of Toxin-Antitoxin Systems in Staphylococcus aureus. Toxins 2018, 10, 473. https://doi.org/10.3390/toxins10110473
Habib G, Zhu Q, Sun B. Bioinformatics and Functional Assessment of Toxin-Antitoxin Systems in Staphylococcus aureus. Toxins. 2018; 10(11):473. https://doi.org/10.3390/toxins10110473
Chicago/Turabian StyleHabib, Gul, Qing Zhu, and Baolin Sun. 2018. "Bioinformatics and Functional Assessment of Toxin-Antitoxin Systems in Staphylococcus aureus" Toxins 10, no. 11: 473. https://doi.org/10.3390/toxins10110473
APA StyleHabib, G., Zhu, Q., & Sun, B. (2018). Bioinformatics and Functional Assessment of Toxin-Antitoxin Systems in Staphylococcus aureus. Toxins, 10(11), 473. https://doi.org/10.3390/toxins10110473

